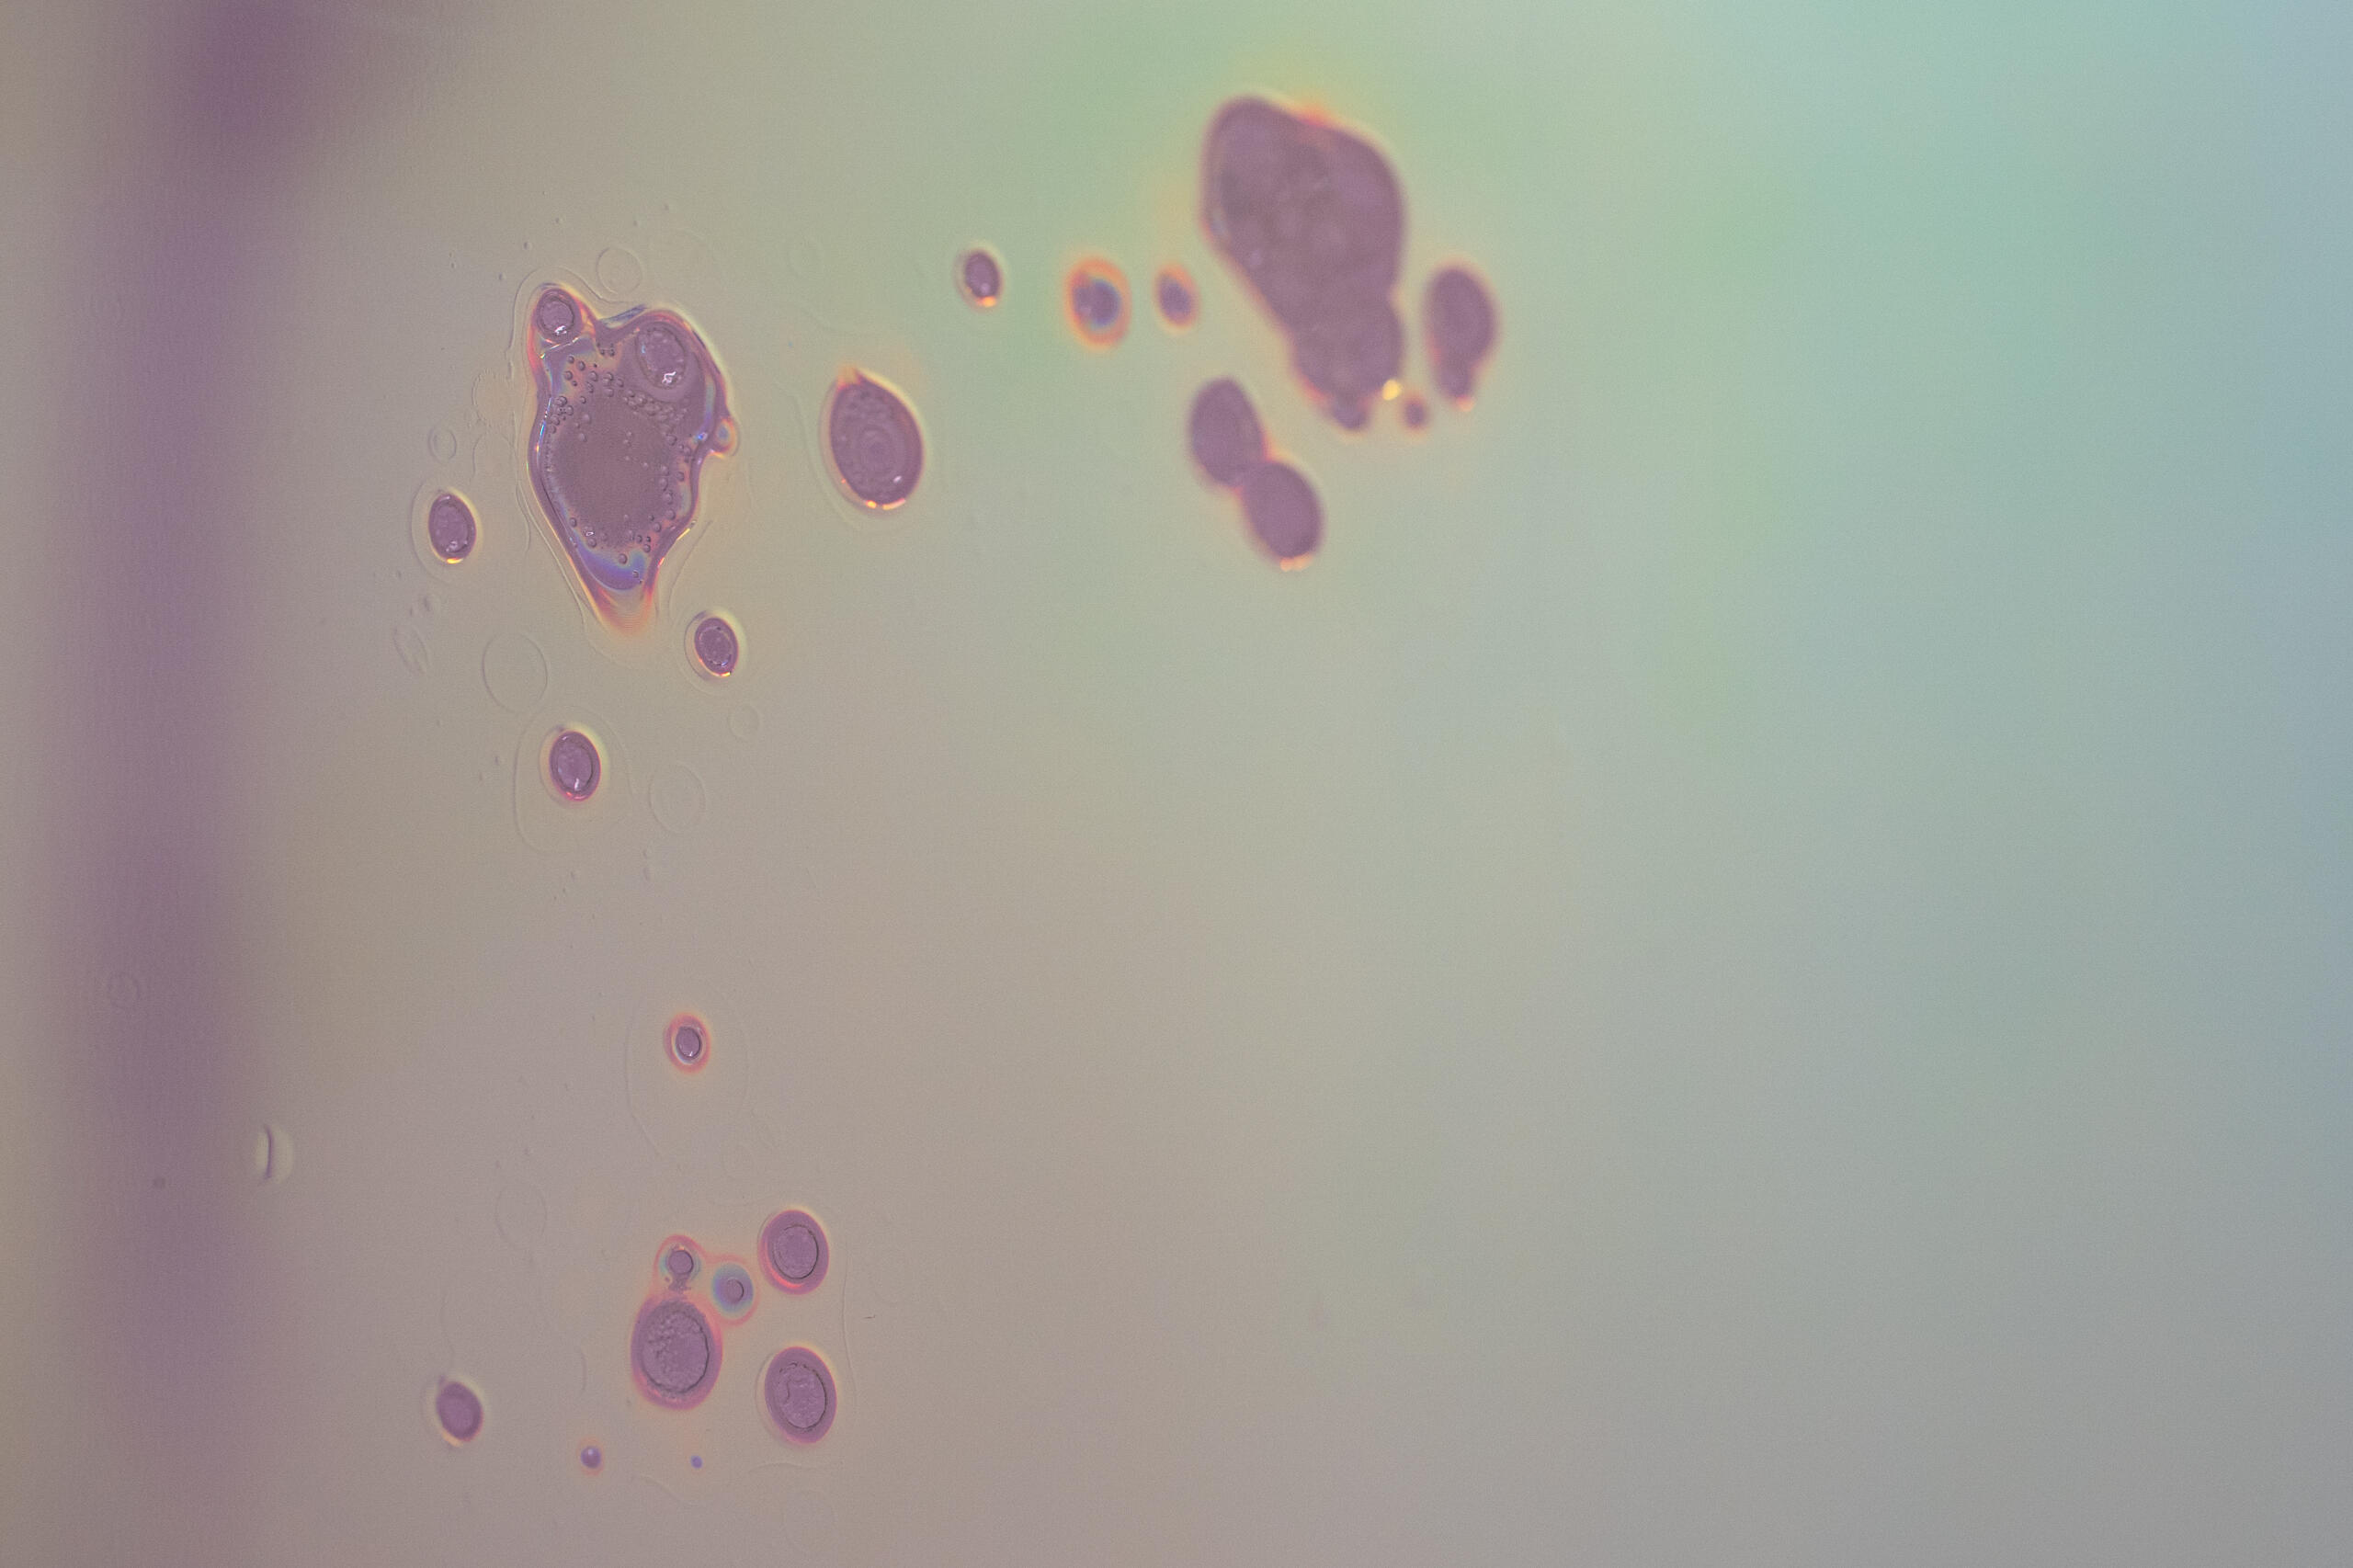

/ PAST WORKS 2021-2022 /
/ FRAMMENTI /












/ WHAT'S LEFT /









/ PELLICOLE DICROICHE /








/ WORKS /
/ NARCISO /




Lodi, 2023
location / Platea
curated by / Niccolò Giacomazzi and Benedetta Monti
The mirror is made of a polyester photographic cloth, overlaid by dichroic film applied on glass.
The blackness gives depth and clarity to the reflected image, creating a dizzying chasm where one’s figure sinks, enriched by shades of color.
Narcissus is a project that explores the intimacy of reflection, self-eroticism and self- satisfaction as a gesture of pure love. The intimate sphere of narcissism is manifested gently, with compassion and affection, leaving out the pathological, violent and negative aspects associated with that word. It restores space to a poetic gesture where the celebration of one’s own image is sweet.
/ TOO FAR FOR LIGHT TO TRAVEL /




Roma, 2024
location / Galleria Valentina Bonomo
Reflecting on the physical and limited nature of light, "Too Far for Light to Travel" looks to the horizon of the observable universe. Fifteen meters of light rays traverse space, a symbolic journey that recalls the fifteen billion light-years, the maximum distance photons can travel before fading into darkness. This boundary marks the limit of our universe, indicating the edges of our knowledge. Beyond it, beyond the limit reached by light, imagination propels us towards the unknown, the mysterious, the sublime, where infinite possibilities extend.
In our modern age, it is at fifteen billion light-years that the poetic line separating knowledge from imagination is found, the boundary between two universes, where the tangible dissolves into the ethereal. One must travel this far to imagine a reality different from the one we live in.
The installation consists of eight transparent plexiglass tubes, wrapped in dichroic film, a material that in the mid-20th century was used by NASA for the visors of astronauts' helmets. This material was chosen because, although transparent, it either prevents or partially allows light and solar radiation to pass through. It is precisely this property that gives tangible physicality to the columns. The light, coming from a simple LED positioned at the end of each column, bounces off its surface, materializing into "spatial" colors and shades.
/ SPACE HOUSE /











Roma, 2024
location / Fondazione Supernova
curated by / Niccolò Giacomazzi
Part of my research explores the notion of reflection, revealing an alternative and parallel dimension to our own. The image in the mirror is not just an optical effect, but a presence that watches us. We are not alone, but fragments, doppelgängers of other worlds. According to the writer and philosopher Jean Paul, the mirror reflects not only what is visible, but also the hidden depths of consciousness, revealing identities and contradictions. Similarly, the mirror of imagination transforms reality, showing us ever-new visions.
In a cosmos of infinite dimensions, we are not the center, but mere shadows, echoes of other existences. Iridescent mirrors become channels of communication between worlds, creating experiences where the viewer perceives that reality itself is an illusion. This reality is a subjective construct, filtered and shaped by our perceptions, which give us a fragmented and unique vision of the world.
/ COLLATERAL DISPLAY /

Roma, 2023
location / Contemporary Cluster
curated by / Davide Mannocchi
Collateral Display is a modular installation, its conformation lacks specificity, showing the quality of natural adaptation from context to context. The work consists of a series of mirrored surfaces of varying colours made of glass, tempera and dichroic film. The work sets itself up as a vehicle for modifying space, acting on both the occupation and deformation of the mirrored image. The use of reflective surfaces generates a short circuit between the eye and the gaze, between observation and understanding.
The mirror object embraces mystical imagery: metaphorically identified by folklore as a demonic instrument, the mirror remains anchored to the concept of vanity and lust. D’Angelo reinterprets this reading by activating with Collateral Display a game of identification and alteration in the spectator. The multiplication of the irregular mirrored surfaces metaphorically replicates the fragmented reality of the contemporary world, its unequivocal disuniformity reinforcing the conviction that today emancipation from an individual vision of existence remains essential. Singular identity is in fact the opposite of art, the fragility of certainties is instead the only axiom capable of supporting the weight of the freedom of the artist.Text by Davide Mannocchi
/ AWAITING /







Roma, 2022
location / Spazio Y
curated by / Benedetta Monti
in collaboration with / Spazio Y and Off1c1na
Seventeen years may pass before cicadas find the ideal conditions to emerge from the underground. Awaiting, an installation created from the remnants of Spazio Y, reflects on perseverance and resilience: the ability to rise again when the context becomes favorable. In the times we are living through, the resilience of cicadas becomes a symbol of hope, reminding us that better days will come.The installation is composed of scrap metal accumulated within the space. Hidden among the sharp forms of the composition are one hundred and fifty cicada exoskeletons, crafted with plaster and resin. A futuristic sound accompanies the work, inviting the viewer to step into the narrow, metallic forest in search of these small insects.
/ DEFAULT ORBIT /





Roma, 2022
location / Blocco 13
curated by / Sonia Andresano
Default Orbit: Without space or time, is a sculptural project centered on the notions of time and space, molded and twisted by a fantastic imagination and a visionary projection of becoming. The sculptures, made from rags, plaster, acrylic, and resin, represent landscape fragments from future worlds, which manifest within real and present landscape contexts, blending reality and imagination. The works are presented as unknown artifacts, fragments magnified through telescopes.
/ LO SGUARDO OLTRE /




Roma, 2022
location / Forte Antenne
curated by / Sonia Andresano
in collaboration with / Fondazione SmArt
Non Ora is a sculptural representation of the stratification of a place. The livid, bright colours of the plaster and resin pseudo-flesh seem to recall a still open wound, a laceration that frightens but at the same time attracts the public. A plastic project that places sculptures that seem to belong to another time and another space in dialogue with each other. Time is transformed into matter, dismembered and reworked in a brutal and sensual play of shapes and colours.Text by Camilla Salvi
/ NON ORA /











/ EXHIBITIONS /
solo exhibitionsToo far for light to travel
→ Galleria Valentina Bonomo (Roma) 2024Space House
→ Fondazione Supernova, curated by Niccolò Giacomazzi (Roma) 2024Narciso
→ Platea, curated by Niccolò Giacomazzi and Benedetta Monti, (Lodi) 2023Default Orbit
→ Blocco 13, curated by Sonia Andresano and Carlo Alberto Bucci (Roma) 2023Awaiting
→ Spazio Y, curated by Benedetta Monti (Roma) 2022
collective exhibitionsTalentPrize
→(third prize winner), Finalists Collective Exhibition,
La Galleria Nazionale GNAM (Rome)
2024
Stato d'Imprevisto
→ Scoletta di S. Giovanni Battista, curated by Flaminia Ciuferri & Niccolò Giacomazzi (Venice)
2024
El Dorado
→ Museo Canonica Villa Borghese, curated by Alessandra Mammì (Roma) 2023
Arte in Nuvola
→ international art fair, Galleria Valentina Bonomo, (Roma) 2023/2024Post Scriptum (duo exhibition)
→ Contemporary Cluster Gallery, curated by Davide Mannocchi, (Roma) 2023+1, One plus One
→ Galleria Valentina Bonomo (Roma) 2023
→ Premio Fregellae, Museo Archeologico di Ceprano, curated by Ilaria Monti (Ceprano) 2022Vacunalia, Il tempo Scortese
→ Vacone curated by Niccolò Giacomazzi and Benedetta Monti (Vacone) 2022Lo sguardo oltre
→ Fondazione SmArt, Collective Exhibition, curated by Sonia Andresano, (Roma) 2022Archeologia del futuro
→ Ladispolenamente, Collective Exhibition, curated by Elisa Selli, (Ladispoli) 2021
/ ABOUT /

I was born in 1993 and began my artistic practice in 2021, focusing primarily on site-specific installations and material experimentation. I trained in restoration, specialising in Baroque decorative techniques such as gold leafing and lacquering at the Nazzareno Fontana Restauri workshop in Rome.
Light, along with the projections it creates and its tangible qualities, has become a fundamental element of my recent work. I place particular emphasis on the concept of space, both in its architectural and scientific dimensions.
My installations draw on the imagery of science fiction, inspired by dystopian visions where perception is distorted and the linearity of existence is disrupted. Through my art, I reflect on the reality we are living by projecting alternative existences.
In making light both a material and a metaphor, my installations invite introspection. The immersive environments I create, where light morphs and colours shift, alter not only the space but also the viewer's perception of that space and, by extension, their perception of reality itself.
Through my work, I invite people to rethink how they perceive the world around them, exploring how we see and also how things can change and be reimagined. I wish to spark conversations about perception, reality, and the potential of human creativity and imagination.
/ CONTACTS /

Valerio D'Angelo is rappresented by Valentina Bonomo
personal e-mail valeriodangelo@proton.me
portfolio download / CV download / instagram
Text










